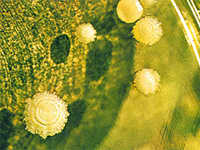

|
Identifican 12 nuevas variantes genéticas que aumentan el riesgo de lupus
 Martes, 20/10/2009 - 15:2
Martes, 20/10/2009 - 15:2
El lupus sistémico eritematoso es una enfermedad autoinmune muy variable en la que el sistema inmune de una persona ataca los tejidos de su propio organismo.
Leer más...
|
|
Descubren un gen que provoca un cáncer poco común
 Sábado, 17/10/2009 - 12:46
Sábado, 17/10/2009 - 12:46
Científicos europeos han identificado un gen que provoca una forma de cáncer poco común denominado carcinoma quístico adenoide (CCA).
Leer más...
|
|
Identifican nuevas regiones genéticas relacionadas con enfermedades sanguíneas
 Jueves, 15/10/2009 - 17:44
Jueves, 15/10/2009 - 17:44
Un equipo internacional llevó a cabo una importante investigación, la cual podría servir para explicar el origen de muchas enfermedades cardiovasculares relacionadas con la coagulación.
Leer más...
|
|
Los europeos son más propensos a infartos por una característica genética en la sangre
 Lunes, 12/10/2009 - 7:59
Lunes, 12/10/2009 - 7:59
Según un estudio, es un componente que, asociado con un mayor número de plaquetas circulantes, incrementa en hasta 15% la posibilidad de tener un infarto.
Leer más...
|
|
Descifran en Brasil genoma de levadura más usada para producir etanol
Sábado, 10/10/2009 - 23:32
Sábado, 10/10/2009 - 23:32
Un equipo de investigadores brasileños y estadounidenses descifró el genoma del hongo 'Saccharomyces cerevisiae', que es la levadura más usada para la fabricación de etanol, lo que abre posibilidades para aumentar la productividad del biocombustible.
Leer más...
|
|
Decodifican la secuencia genética de un tumor de seno
 Viernes, 9/10/2009 - 12:3
Viernes, 9/10/2009 - 12:3
Científicos canadienses anunciaron el miércoles haber logrado decodificar por primera vez la secuencia genética de un tumor canceroso de seno y haber identificado las mutaciones que permiten la propagación del cáncer.
Leer más...
|
|
El sistema de castas ha existido en la India se remonta a milenios
 Sábado, 26/9/2009 - 14:40
Sábado, 26/9/2009 - 14:40
El sistema de castas ha existido en la India desde hace miles de años, según un estudio de la Escuela de Medicina de Harvard en Boston (Estados Unidos) que se publica en la revista 'Nature'.
Leer más...
|
|
3.000 millones de letras componen el ADN de cada especie
 Martes, 22/9/2009 - 16:49
Martes, 22/9/2009 - 16:49
Ahora se puede reconstruir la historia de las especies con absoluta precisión, si se invierten esfuerzos y recursos para desentrañar los 3.000 millones de letras que componen el ADN de cada especie.
Leer más...
|
|
Científicos europeos descubren tres nuevos genes relacionados con el alzheimer
 Martes, 15/9/2009 - 8:39
Martes, 15/9/2009 - 8:39
Un equipo científico europeo, en el que participan dos asturianos, ha descubierto tres nuevos genes relacionados con el alzheimer. Según los responsables del estudio el hallazgo podría reducir en un 20 por ciento la cantidad de gente que desarrolla la enfermedad.
Leer más...
|
|
El gusano de seda revela su historia de más de 5.000 años
 Sábado, 5/9/2009 - 23:7
Sábado, 5/9/2009 - 23:7
La selección artificial de los gusanos ha actuado a lo largo de miles de años favoreciendo características de interés económico como el mayor tamaño del capullo, la superior expresión de la glándula productora de seda o la alta tasa de crecimiento y de reproducción, señalan los investigadores.
Leer más...
|
|
Sólo tres genes controlan la variedad de pelaje en los perros
 Miércoles, 2/9/2009 - 16:17
Miércoles, 2/9/2009 - 16:17
El trabajo, que se publica en la revista Science es de utilidad para comprender mejor las enfermedades humanas causadas por variaciones en más de un gen (poligénicas).
Leer más...
|
|
Identifican un mecanismo de inestabilidad genómica
 Martes, 1/9/2009 - 8:31
Martes, 1/9/2009 - 8:31
La investigación, que aparece publicada en el último número de la revista Nature Cell Biology, es de interés para comprender cómo se realiza el reparto de cromosomas entre la célula madre y sus hijas y cómo se originan las alteraciones en el contenido del genoma.
Leer más...
|
|
¿Por qué algunas personas necesitan dormir menos horas?
 Martes, 18/8/2009 - 8:35
Martes, 18/8/2009 - 8:35
Algunas personas necesitan ocho o nueve horas para poder estar activas por la mañana, mientras que para otras son suficientes cinco o seis, e incluso menos, sin que se les cierren los párpados ni den un bostezo al día siguiente.
Leer más...
|
|
Una variante genética en el cromosoma X frena el avance del sida en algunas mujeres
 Lunes, 17/8/2009 - 23:14
Lunes, 17/8/2009 - 23:14
Unos investigadores alemanes han relacionado, por primera vez, una variante genética en el cromosoma X con un avance más lento del sida en las mujeres. Sin embargo, en los hombres con la misma variante no se ha demostrado este efecto.
Leer más...
|
|
11 |







